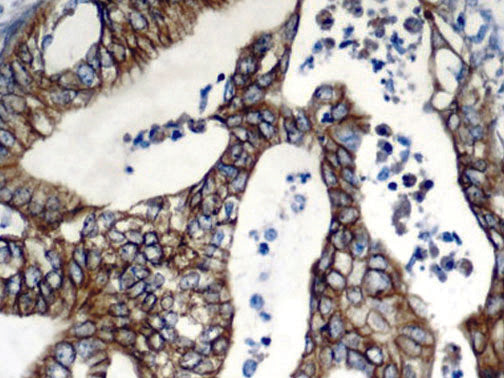

EGFR – MMab
EGFR is a Mouse monoclonal antibody derived from cell culture supernatant that is concentrated, dialyzed, filter sterilized and diluted in buffer pH 7.5, containing BSA and sodium azide as a preservative.
Special Note EGRF antibody requires the use of ImmunoDNA Digestor (Cat.#’s BSB 0108, BSB 0109, BSB 0110, BSB 0111, BSB 0112) or similar Proteinase K based product as antigen retriever.
Intended Use
Summary and Explanation
Presentation
Choose options
EGFR – MMab
Sale priceFrom $179.00